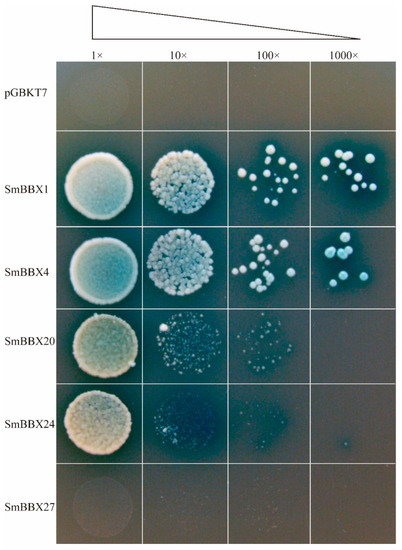

Abstract
B-box (BBX) is a type of zinc finger transcription factor that contains a B-box domain. BBX transcription factors play important roles in plant photomorphogenesis, signal transduction, as well as abiotic and biological stress responses. However, the BBX gene family of Salvia miltiorrhiza has not been systematically investigated to date. For this study, based on the genomic data of Salvia miltiorrhiza, 27 SmBBXs genes were identified and clustered into five evolutionary branches according to phylogenetic analysis. The promoter analysis suggested that SmBBXs may be involved in the regulation of the light responses, hormones, stress signals, and tissue-specific development. Based on the transcriptome data, the expression patterns of SmBBXs under different abiotic stresses and plant hormones were analyzed. The results revealed that the expressions of the SmBBXs genes varied under different conditions and may play essential roles in growth and development. The transient expression analysis implied that SmBBX1, SmBBX4, SmBBX9, SmBBX20, and SmBBX27 were in the nucleus. A transcriptional activation assay showed SmBBX1, SmBBX4, SmBBX20, and SmBBX24 had transactivation activities, while SmBBX27 had none. These results provided a basis for further research on the role of SmBBXs in the development of Salvia miltiorrhiza.
1. Introduction
B-box (BBX) proteins are a class of zinc finger transcription factors that contain one or two B-box domains, with some members having CCT (CONSTANS, Co-like, and TOC1) domains [1]. BBX gene family members have been identified in several species (e.g., 32 BBX genes in Arabidopsis thaliana [2], 30 in Oryza sativa [3], 27 in Phyllostachys edulis [4], 28 in Fagopyrum tataricum [5], 43 in Brassica rapa [6], and 31 in Solanum lycopersicum) [7].
BBX proteins are extensively involved in various plant growth and development processes [8], such as secondary metabolite synthesis, photomorphogenesis, flowering, signal transduction, abiotic and biological stress responses [9], etc. The MdBBX22-miR858-MdMYB9/11/12 module cooperates to regulate the accumulation of proanthocyanidins in apple peel [10]. In Malus pumila, MdBBX37 inhibits anthocyanin biosynthesis and promotes a hypocotyl elongation by negatively regulating the photosignaling pathway [11]. MdBBX37 integrates light, JA (jasmonic acid), ABA (abscisic acid), and ethylene signaling to regulate the leaf senescence by interacting with MdbHLH93, MdABI5, and MdEIL1 [12]. In Solanum lycopersicum, SlBBX20 activates the expression of SlDFR by binding to G-box1 in the promoter region of SlDFR, thus promoting anthocyanin biosynthesis [13]. The S. lycopersicum transcription factor module SlBBX20/21-SlHY5 regulates the photomorphogenesis of tomato [14]. The activities of AtCOP1 were inhibited under light exposure, resulting in the accumulation of AtBBX28 and AtHY5, where AtHY5 regulates the expression of many downstream target genes to promote photomorphogenesis [15]. BBX28 and BBX29 play important roles in facilitating the integration of light and brassinosteroid signals to regulate plant morphogenesis [16]. In A. thaliana, BBX16 induces and promotes photomorphogenesis under moderate light and is inhibited by GUN1/GLK1 following chloroplast damage [17]. The overexpression of AtBBX18 and AtBBX19 in A. thaliana can significantly prolong circadian cycles [18], whereas AtBBX7/AtBBX8 can positively regulate the frost resistance of plants [19]. Furthermore, the heterologous expression of CmBBX22 can delay leaf senescence in A. thaliana [20]. With deeper research, the molecular functions and regulatory networks of BBX in different plants have been revealed, which has attracted increasing attention to the field of plant molecular genetics.
S. miltiorrhiza is known as a model medicinal plant due to its small genome and perfect transgenic system, which has an exceptionally high therapeutic value [21,22,23]. However, the BBX gene family in S. miltiorrhiza has not yet been identified via functional analysis. We identified 27 SmBBXs genes based on the whole-genome data analysis of S. miltiorrhiza. From the cis-element analysis results, the homologous protein analysis of S. miltiorrhiza and A. thaliana, and the protein interaction prediction results, we selected SmBBX1/4/20/24/27 as the candidate genes for transcription activation experiments. Subsequently, according to previous reports [24,25,26,27,28], transcriptome data were selected to analyze the transcription levels of SmBBXs under various plant hormones (GA3 and ABA) and stress treatments (NaCl and PEG). These results laid a foundation for a further study on the functional characteristics of BBX genes in S. miltiorrhiza.
2. Results
2.1. Identification of SmBBXs Genes
Based on gene annotations and the conserved B-box motif characteristics of the BBX members, a total of 27 SmBBX genes were identified, with the detailed data for each SmBBX presented in Table 1. The amino acid (AA) lengths of the 27 SmBBXs ranged from 149 aa (SmBBX12) to 430 aa (SmBBX25), while the molecular weights of all proteins were 16–48 kD (SmBBX12 and SmBBX14). The Pl (isoelectric point) of all SmBBXs was lower than seven, which indicated that all SmBBXs were acidic proteins, with the most acidic being SmBBX13. Additionally, it was found that all SmBBXs were hydrophilic proteins, among which the SmBBX15 exhibited the greatest hydrophilicity. Except for SmBBX16, SmBBX19, and SmBBX22, most SmBBXs had instability indices of >40 and were therefore classified as unstable proteins. All SmBBXs were localized in the nucleus without signal peptides (Supplementary Figure S1) and transmembrane domains (Supplementary Figure S2).

Table 1.
Nomenclature, CDS, peptide lengths, molecular weights (MW), theoretical isoelectric points (PI), instability and aliphatic indices, Grand Average of Hydropathicity (GRAVY) and subcellular localization of Salvia miltiorrhiza BBX gene family.
2.2. Protein Sequences and Phylogenetic Analyses of SmBBXs
The domain logos and sequences of the B-box1, B-box2, and CCT domains of the SmBBX proteins are shown in Figure 1. Six members of the 27 SmBBXs were characterized by the occurrence of two B-box domains and a conserved CCT domain. Only two B-box domains were found in six SmBBXs, whereas eight members had one B-box domain and a CCT domain, and seven had only one B-box domain (Table 2). Among the three domains, we found that the BBX motif contained ∼43 residues with the consensus sequence C-X2-C-X8-C-X7-C-X2-C-D-X3-H-X8-H-X4 (Figure 1). Additionally, the consensus sequence of the conserved CCT domain was K-X2-R-Y-X2-R-K-X2-R-K-X2-A-X2-R-X-R-X-K-G-R-F (Figure 1).

Figure 1.
Composition of SmmBBXs protein domains. (A) Amino acid sequence alignment of B-box1, B-box2, and CCT domains. The y-axis indicated the conservation rate of each amino acid, the x-axis indicated the conserved sequences of the domain. (B) Multiple sequence alignments of the SmBBXs domains. Multiple sequence alignments of B-box1, B-box2, and CCT domains are shown. Identical conserved amino acids are highlighted black.

Table 2.
SmBBXs protein structures.
Depending on the domain, we identified four distinct types of BBX proteins: SmBBXs with two B-boxes and one CCT domain, SmBBXs with one B-box and one CCT domain, SmBBXs with two B-boxes, and SmBBXs with one B-box domain. To better reveal the evolutionary relationships, we generated a phylogenetic tree with the known BBX families from Arabidopsis and Oryza sativa (Figure 2). All SmBBX protein sequences were clustered into five subfamilies. In group 1 (except for SmBBX3, which had only one BBX and one CCT domain), all other SmBBXs had two BBX domains and one CCT domain. In group 2 (except for SmBBX5, SmBBX6, SmBBX9, and SmBBX25, which had only one BBX domain and one CCT domain), all other SmBBXs had two BBX domains and one CCT domain. In group 3, all SmBBXs had BBX and CCT domains. In group 4 (except for SmBBX19, which had only one BBX domain), all other SmBBXs had two BBX domains. In the group 5 (except for SmBBX6, which had both BBX and CCT domains), the other SmBBXs had only one BBX domain.

Figure 2.
Molecular phylogenetic analysis of SmBBXs protein in Salvia miltiorrhiza. The phylogenetic tree using MEGA X with the neighbor-joining (NJ) method. The number at the branch represents the confidence value obtained by 1000 bootstrap tests. Eighty-nine BBX proteins were divided into five subclasses represented by different colored clusters. Red, orange, blue, purple, and green clusters represent subclasses I, II, III, IV, and V, respectively. Red stars, violet circles, and teal triangles represent Salvia miltiorrhiza, Arabidopsis thaliana, and Oryza sativa, respectively.
2.3. Analysis of cis-Elements in SmBBXs Promoter Region
A total of 63 major cis-elements were predicted in the SmBBXs gene promoter region (Figure 3A), including 26 light-responsive, 13 hormone-responsive, 16 stress-responsive, and 8 tissue-specific and development-related elements. The number of light-responsive cis-elements was largest in the 26 SmBBXs gene promoters (Figure 3A), wherein the total number of light-responsive elements was the largest, including G-box (27.5%), Box4 (26.6%), and GT1-motif (8.0%). The main stress responding cis-elements included STRE (25.5%), MYB (19.7%), and ARE (anaerobic cis-regulatory element) (15.6%). The main hormone responsive cis-elements included ABRE (involved in abscisic acid response) (23.0%), the AAGAA-motif (12.7%), the CGTCA-motif (methyl jasmonate-responsive cis-regulatory element) (12.4%), and the TGACG-motif (12.4%). The primary tissue-specific and development-related cis-elements included O2-site (involved in the regulation of the zein metabolism) (30.9%), CAT-box (meristem-specific expression elements) (20.0%), and CCGTCC-box (meristem-specific expression elements) (16.4%) (Figure 3B). Our findings suggested that the promoter region that contained the SmBBXs gene played a critical role in the photonic and hormone responses.

Figure 3.
Inspection of cis-element in SmBBXs genes. (A) The numbers of different promoter elements in these SmBBX genes are indicated by different colors and numbers in the grid. (B) Different colored histograms represent the sum of cis-elements in each category. Pie charts represent the ratios of each promoter element in each category.
2.4. Calculation of Ka/Ks Values for Homologous SmBBXs Gene Pairs
It was predicted that all Ka/Ks were less <1, which indicated that these SmBBXs proteins underwent a selective evolutionary purification and tended to be stable (Table 3). This was conducive to maintaining functional conservation in the gene families. Furthermore, there were significant variations in the Ka/Ks values between different groups, which implied that they were subject to various degrees of selection pressure and evolutionary rates. For example, the SmBBX7&SmBBX8 group had the highest Ka/Ks value, which translated to an expedited rate of evolution. In contrast, the SmBBX18&SmBBX19 group had the smallest Ka/Ks value, meaning that its amino acid sites were more conserved and less prone to change.

Table 3.
Ka/Ks ratios between paralogous SmBBXs pairs in Salvia miltiorrhiza.
2.5. Gene Structure, Motifs, and Sequence Analysis of SmBBXs
To further understand the genetic structural characteristics of the SmBBXs gene, its introns and exons were analyzed, and the results are shown in Figure 4. The number of exons ranged from one to five, as did the number of introns. Based on the phylogenetic analysis, the SmBBXs gene family was divided into five subgroups. The gene members in the same subgroup had the same (or similar) numbers of exons (e.g., two exons and one intron in group 3 and four exons in group 2).

Figure 4.
Evolutionary tree, conserved motifs, and gene structures of SmBBXs gene family. (A) Phylogenetic relationship of SmBBXs proteins. Five subgroups (groups 1–5) are indicated in different colors; (B) conserved motifs of SmBBX proteins. The size of the conservative motif is proportional to the square size; (C) structure of SmBBX genes. Green rectangles refer to UTR, and yellow rectangles refer to CDS.
Motifs play a role in protein–protein interactions and transcriptional regulation, where their diversity represents that of the protein composition. An online analysis of 27 SmBBXs genes using MEME revealed a total of 20 major motif sequences, among which motif4, motif1, and motif14 were the most widely distributed. Compared with the results of the analysis of the conserved motifs above, motif1 was intimately related to the formation of the B-box1 and B-box2 domains, whereas Motif2 was closely related to the CCT domains. SmBBX11, SmBBX22, SmBBX13, and SmBBX24 possess two motif-1 domains, while all others contain one motif-1. Motif2 exists in group 1, group 2, and group 3, and motif15 exists only in group 3.
2.6. Analysis of Protein–Protein Interactions in SmBBXs
OrthoVenn2 was employed to conduct a homology comparison between S. miltiorrhiza and A. thaliana, which identified 16 SmBBXs orthologous genes in A. thaliana (Table 4). According to the orthologous genes of A. thaliana, a SmBBX protein interaction network was developed using the STRING website (Figure 5), with a focus on the interactions between HY5, COP1, and BBXs. In protein mutual mapping, AtBZS1/AtLZF1/AtBBX21/AtSTO, and COP1 form an interesting HY5 triangle.

Table 4.
Homologous Arabidopsis thaliana and Salvia miltiorrhiza genes of the BBX family.

Figure 5.
Protein–protein interaction networks of SmBBXs proteins. The thickness of the line reflects the strength of the interaction between the proteins.
2.7. Analysis of GO and KEGG in SmBBXs
In order to further explore the function of SmBBXs, GO analysis and KEGG analysis are performed (Figure 6). At the biological process level, SmBBXs were primarily enriched for cellular (GO:0009987), metabolic (GO:0008152), and single-organism processes (GO:0044699). At the molecular function level, SmBBXs were enriched for their catalytic activities (GO:0003824), binding (GO:0005488), and molecular function regulation (GO:0098772). At the cellular component level, SmBBXs were primarily enriched for their cells (GO:0005623), cell components (GO:0044464), and organelles (GO:0043226). KEGG predicted that the major enriched metabolic pathways in SmBBXs were primarily involved in the lipid metabolism, as well as global and overview maps.

Figure 6.
Annotation results. (A) GO terms enriched with SmBBXs, (B) KEGG pathway terms enriched with SmBBXs.
2.8. Subcellular Localization and Transcription Activation of SmBBX Genes
According to the amino acid sequences of the SmBBXs family genes, the Plant-mPLoc online tool was utilized to predict the subcellular localization. We forecasted that 27 SmBBXs were localized in the nucleus, which indicated that the subcellular localization and differentiation of the SmBBXs family proteins were highly conserved. To obtain the subcellular localization of SmBBXs, those of SmBBX1, SmBBX4, SmBBX9, SmBBX20, and SmBBX27 were investigated by the transient expression in onion epidermal cells using a SmBBX transgene fused to a green fluorescent protein (GFP) driven by a CaMV35S promoter. The empty vector was used as the control, with the results showing that it was distributed throughout the cell. This experiment revealed that the SmBBX-GFP activity was located in the nucleus (Figure 7), which was consistent with the bioinformatics prediction (Table 1).

Figure 7.
Subcellular localization analysis. All candidate genes were independently cloned into vector pEarleyGate103. Subcellular localization of SmBBX1-GFP, SmBBX4-GFP, SmBBX9-GFP, SmBBX20-GFP, and SmBBX27-GFP in the nucleus was confirmed in onions via laser confocal microscopy. Scale bars = 100 μm.
The SmBBXs were further fused to the DNA binding domain (BD) to investigate the transcription activation in the yeast cells. Both the negative control pGBKT7 construct and pGBKT7-SmBBX27 were unable to grow on the SD/-Trp-His-Ade that contained X-α-gal medium, whereas the pGBKT7-SmBBX1, pGBKT7-SmBBX4, pGBKT7-SmBBX20, and pGBKT7-SmBBX24 constructs grew quite well on both media. According to the results (Figure 8), the SmBBX1 and SmBBX4 exhibited a more robust transcription activation, while SmBBX27 did not.
Figure 8.
Transcriptional activities of SmBBX TFs in yeast. SD/Trp-/His-/Ade-medium containing 5 mg/mL X-α-gal. The empty pGBKT7 is the negative control. Concentration gradients: 1×, 10×, 100×, 1000×.
2.9. Expression Profiles of SmBBXs Genes
According to the FPKM (Fragments per Kilobase million) values of the SmBBXs family genes in the transcriptome sequencing results, the expressions of the SmBBXs family genes under root, stem, leaf, flower, and abiotic stress were analyzed. TBtools was used to plot the heat map.
The expressions of the SmBBXs genes were different for the various organs of Salvia miltiorrhiza (Figure 9A). SmBBX27, SmBBX1, SmBBX13, SmBBX16, SmBBX18, SmBBX23, SmBBX19, SmBBX26, SmBBX24, SmBBX11, and SmBBX17 had high expression levels in the roots, stems, leaves, and flowers of Salvia miltiorrhiza. The expression levels of SmBBX4, SmBBX8, SmBBX6, SmBBX12, SmBBX15, SmBBX7, SmBBX3, SmBBX2, SmBBX25, and SmBBX9 in all tissues were low. SmBBX5, SmBBX14, SmBBX20, and SmBBX22 were negligibly expressed in all tissues. This indicated that the expression specificities of SmBBXs genes in different tissues were related to their various functions.

Figure 9.
Expression profiles of SmBBX genes in Salvia miltiorrhiza. (A) Expression patterns of Salvia miltiorrhiza roots, stem, leaves, and flowers. (B) Expression patterns of Salvia miltiorrhiza at 0 h, 3 h, and 12 h following GA treatment. (C) Expression patterns of Salvia miltiorrhiza at 0 h, 3 h, and 12 h after ABA treatment. (D) Expression patterns of Salvia miltiorrhiza at 0 h, 3 h, and 12 h after NaCl treatment. (E) Expression patterns of Salvia miltiorrhiza at 0 h, 1 day, and 6 days after PEG treatment. Blue and red indicate downregulated and upregulated expression levels, respectively, compared to the relevant controls (0 h). The bar on the top right corner represents log2 transformed values.
To confirm whether the expressions of SmBBXs were affected by different stressors (based on the cis-element analysis results of SmBBXs and the literature reports), the transcriptome data of the four treatments (GA3, ABA, PEG, and NaCl) were utilized to analyze the transcript abundance.
Under the GA3 treatment (Figure 9B), the expression of SmBBXs did not have a relatively consistent trend, and the expression of most SmBBXs members was not significantly altered. Interestingly, the expressions of SmBBX3/14/16/17/10/4/13 increased quickly at 3 h and then decreased rapidly at 12 h. In contrast, the SmBBX5/12/18/19/27/2/26 expression levels dropped rapidly at 3h, which then quickly rebounded at 12 h. Under ABA treatment (Figure 9C), except for the elevated expression levels of SmBBX5/12/20/21/22/23/6/27, the expression levels of other genes decreased, but the expression levels of SmBBX13/3/25 tended to increase at 12 h. A similar situation was observed under the NaCl treatment (Figure 9D) where, except for the upregulated expressions of SmBBX5/26/27/20/25/16/22, the other genes were downregulated; however, SmBBX6/7/9/21/8/23 showed an upregulated expression trend at 12 h. Under the PEG treatment (Figure 9E), the expressions of SmBBX16/5/20/6/22/25/23/18/21 were gradually upregulated over six days, while the other gene expressions were downregulated and relatively specialized. The expressions of SmBBX24/12/27 were up-regulated on the first day and then downregulated on the sixth day.
3. Discussion
As a class of zinc finger proteins, BBX transcription factors are extensively involved in various plant growth and development processes. They are engaged in many light signal pathways in plants and have certain functions against biotic and abiotic stress. The roles of BBX genes in medicinal plants have rarely been studied. However, they are involved in light morphogenesis, flower development, shade avoidance effects, plant signal transduction, and abiotic and biotic stress responses, which are also critical for the production and breeding of medicinal plants. Therefore, it is necessary to further investigate the functions of BBX genes in essential medicinal plants. In this study, the members of the BBX transcription factor family of Salvia miltiorrhiza were identified by BLAST alignment and conserved domain analysis. A total of 27 BBXs transcription factors were identified from the entire genome of S. miltiorrhiza, and their phylogenetic trees, cis-element, gene structures, subcellular localizations, autoactivation functions, hormone treatments, and stress tolerance expression patterns under abiotic stress were analyzed.
Numerous photoresponsive elements (e.g., Box4, G-box, and CTT-motifs) were distributed on the SmBBXs promoter sequence. Hormone response elements included the ABRE (abscisic acid response element), the TCA-element (salicylic acid response element), the TATC-box (gibberellin response element), the CGTCA-motif (jasmonic acid response element), etc. The abiotic stress response elements included the MBS (salt stress response elements and drought-induced MYB transcription factor binding sites), DRE (against high salt stress), and TC-rich repeats (against drought stress and pest stress). The Cis-element analysis indicated that the SmBBXs family might play an important role in light signals, hormones, and abiotic stresses. For example, SmBBX4 is highly expressed in leaves but minimally expressed in other tissues, while SmBBX17 is highly expressed in all tissues, indicating that the functions of SmBBXs vary in different tissues.
For this study, transcriptome data were used to further analyze the expressions of SmBBXs under GA3, ABA, salt stress, and drought treatments, with the results revealed that most SmBBXs were responsive. It was observed that CmBBX19 and ABF3 complexes can regulate plant drought tolerance through an ABA-dependent pathway [29]. The overexpression of AtBBX5 enhances the salt tolerance of transgenic Arabidopsis through an ABA-dependent pathway [30], while SmBBX11 (a direct homolog of AtBBX5) is differentially expressed under salt stress and an ABA treatment. SmBBX11 may function similarly to AtBBX5 and participate in the salt-stress responses through an ABA-dependent pathway.
The two BBX conserved domains of SmBBXs transcription factors are very similar to those of Oryza sativa BBX and pepper BBX. The CCT domain of SmBBXs is similar to the CCT domain of pepper, indicating that BBX and CCT domains are strongly conserved between species. In SmBBXs, the sequence identity of the B-box1 domain was 58.75%, while that of the B-box2 domain was 58.33%, and that of the CCT domain was 73.21%; thus, the three SmBBXs domains were conserved. Conserved domains play significant roles in mediating protein interactions and regulating the gene expression. The B-box domain is thought to be required for interactions with HY5 and transcriptional regulation, as the AtBBX25 functions by interacting with HY5 through its B-boxes. The second B-box in AtSTH3 is important for HY5–STH3 interactions. AtBBX24 can form a heterodimer with HY5, which interferes with the binding of HY5 to the anthocyanin biosynthesis gene promoter, and thus inhibits their expressions [31]. PpBBX18 forms heterodimers with PpHY5 through two B-box domains and induces PpMYB10 transcription [32]. PtrHY5 enhances the activation of PtrBBX23 to downstream genes by interacting with the second B-box at the N-terminal of the PtrBBX23 gene through the C-terminal bZIP domain [33].
Anthocyanins belong to biological flavonoids, which are a type of water-soluble natural pigment. For plants, anthocyanins serve as natural photoprotectants that can remove oxygen free radicals to protect them from strong light burns, absorb excess visible light, protect against UV rays, and help plants resist biotic and abiotic stresses [34]. In the human body, anthocyanins confer potent antioxidant capacities, which have an important medical value (e.g., anti-tumor, anti-aging, anti-fatigue, the regulation of intestinal flora, and the lowering of blood lipids) [35,36]. As a model medicinal plant, it is of great significance for studying the synthetic kinetics of anthocyanins. In A. thaliana, BBXs proteins were involved in the photomorphogenesis of seedlings and photoinduction responses and formed a common regulatory module with COP1 and HY5 proteins [37,38] to participate in the transcriptional regulation of anthocyanin synthesis in plants [39]. In the dark, COP1 mediates the degradation of BBX and HY5 via the 26S proteasome system to promote dark morphogenesis. Under light exposure, COP1s activity is inhibited in a photo dependent manner, which allows BBX and HY5 to accumulate to promote photomorphogenesis. BBX interacts with HY5, interferes with the binding of HY5 to the target, and inhibits the transcriptional activity of HY5, thus negatively regulating photomorphogenesis. Based on the mapping of the A. thaliana protein interaction network, it was speculated that SmBBX20 might also regulate anthocyanin synthesis through a co-regulation with COP1 and HY5 [40].
At the genome-wide level, we analyzed the direct homologs of A. thaliana and S. miltiorrhiza genes and selected 16 direct homologs of SmBBXs from A. thaliana to perform interactive protein mapping to plot the potential functions of SmBBXs. In protein mutual mapping, AtBZS1/AtLZF1/AtBBX21/AtSTO and COP1 form an interesting HY5 triangle. We hypothesized that SmBBX20/SmBBX21/SmBBX23/SmBBX24, COP1, and HY5 proteins comprise a common control module which is involved in the transcriptional regulation of anthocyanin synthesis in S. miltiorrhiza. This will need to be verified through subsequent experiments.
Since eukaryote transcription processes primarily occur in the nucleus, this is typically where transcription factors are found. According to the phylogenetic tree, 27 SmBBXs were divided into five groups, and one gene was selected from each of them to verify the subcellular localization results (Figure 7). The experimental results were consistent with the prediction, as the SmBBX1/SmBBX4/SmBBX9/SmBBX20/SmBBX27 localization in the nucleus revealed them as transcription factors with regulating roles in the cell nucleus.
The transformation of yeast via instantaneous measurements indicated that SmBBX1/SmBBX4/SmBBX20/SmBBX24 had transactivation activities. Therefore, in S. miltiorrhiza, SmBBX1/SmBBX4/SmBBX20/SmBBX24 likely serve as downstream gene transcription activation factors.
4. Materials and Methods
4.1. Genome-Wide Identification of BBX Genes in S. miltiorrhiza
To identify all of the BBX proteins in S. miltiorrhiza, its genome file was initially download from the China Traditional Chinese Medicine Data Center (https://ngdc.cncb.ac.cn/, accessed on 6 April 2022), while the BBX protein sequence of A. thaliana was downloaded from the TAIR database (https://www.arabidopsis.org/, accessed on 6 April 2022) [41]. Further, the Oryza sativa BBX sequence was downloaded from the Rice Genome Annotation Project (http://rice.plantbiology.msu.edu/, accessed on 6 April 2022) [42]. The A. thaliana BBX and S. miltiorrhiza protein data were compared using Local Blastp (Expectation value = 1.0) with BioEdit software (Borland, Scotts Valley, CA, USA). This study set the E value during the search as 0.001 to obtain the candidate SmBBXs protein sequences, which were submitted to the InterProScan database (https://www.ebi.ac.uk/interpro/, accessed on 6 April 2022), Pfam database (https://www.ebi.ac.uk/Tools/pfa/pfamscan/, accessed on 6 April 2022) [43], CD-search (https://www.ncbi.nlm.nih.gov/cdd/, accessed on 6 April 2022), and SMART (http://smart.embl-heidelberg.de/smart/, accessed on 6 April 2022) [44]. This further confirmed that the SmBBXs sequence contained the B-box domain, and that there were 27 BBX protein gene sequences in S. miltiorrhiza.
4.2. Sequence Alignment and Phylogenetic Analysis
The phylogenetic tree can visually display the homologic relationships between genes. Thus, to determine the evolutionary relationships between BBXs genes, phylogenetic trees for AtBBXs, OsBBXs, and SmBBXs proteins were developed with MEGA X software [45] using the neighbor-joining method (NJ). Test of phylogeny: the bootstrap method, No. of bootstrap replications: 1000, model/method: p-distance, rates between sites: uniform rates, gaps/missing data treatment: pairwise deletion, and number of threads: 7. Evolutionary tree beautification was performed using the online website Evolview (http://www.evolgenius.info/evolview/, accessed on 6 April 2022). The sequences of the three conserved regions of SmBBXs BBX1, BBX2, and CCT were multiply aligned using ClustalW [46], and the sequence identification was constructed online (http://weblogo.berkeley.edu/logo.cgi, accessed on 6 April 2022).
4.3. Protein Properties, Exon and Intron Distribution, and Conserved Motif Analysis
The 27 SmBBXs gene sequences were submitted to the ProtParam tool (https://web.expasy.org/protparam/, accessed on 6 April 2022) [47] for the amino acid number, molecular weight, isoelectric point, protein instability index, Aliphatic index, and GRAVY of the SmBBXs. Predicting the subcellular distribution of SmBBXs was useful in deducing the potential functions of the SmBBXs. Plant-mPLoc (http://www.csbio.sjtu.edu.cn/bioinf/plant-multi/, accessed on 6 April 2022) was used for the subcellular localization analysis. Transmembrane domain analysis was performed using TMHMM Server v. 2.0 (https://services.healthtech.dtu.dk/, accessed on 6 April 2022), whereas the signal peptide prediction was performed using SignalP (http://www.cbs.dtu.dk/services/SignalP/, accessed on 6 April 2022).
For this study, the diversity of the SmBBXs protein motif compositions was investigated using the MEME online website (https://meme-suite.org/meme/tools/meme, accessed on 6 April 2022) [48]. The maximum number of motifs was set to 8, and the motif length was set to 6–200 amino acids, while other parameters were set by default. Tbtools v1.089 software (Chengjie Chen et al., China) [49] was used to visualize the intron and exon structures of the SmBBXs gene. This study also employed PSIPRED (http://bioinf.cs.ucl.ac.uk/psipred/, accessed on 6 April 2022) online software to predict the secondary structures of the SmBBXs protein.
4.4. Cis-Element Analysis for BBX Gene Promoters
To analyze the potential tissue-specific and developmental hormone responses, stress responses, and light response-related cis-elements of the SmBBXs gene, the 2000 bp upstream (ATG) promoter sequences of the 27 SmBBXs gene initiation codons were employed using the online PlantCARE website [50], to predict the cis-elements of SmBBXs and count the light-responsive, hormone-responsive, stress-responsive, tissue-specific, and developmental-related elements.
4.5. Calculation of Ka/Ks Values for Homologous SmBBXs Gene Pairs
The Ka and Ks values of the homologous genes were calculated using PAL2NAL (http://www.bork.embl.de/pal2nal/, accessed on 6 April 2022) to predict how they were evolutionarily selected. Among them, when Ka/Ks > 1, the gene was considered to be under a positive selective pressure, more likely to produce non-synonymous mutations and cause changes in the amino acid sequence. When Ka/Ks = 1, the gene was considered to be under neutral selective pressure, whereas when Ka/Ks < 1, it was considered to be under negative selective pressure and more inclined to produce synonymous mutations, thereby maintaining the stability.
4.6. Gene Ontology (GO) and KEGG Annotation
GO analysis was performed on the SmBBXs family, which encompassed the biological processes, cellular components, and molecular functions. Enrichment was intuitively displayed through the distribution of differential genes on the GO enrichment histogram, which facilitated molecular analysis. To elucidate the various levels of protein functionality, KEGG was employed to analyze the metabolic and transduction pathways in which the SmBBXs gene family was primarily involved in the systematic study of the SmBBXs functional and expression data. GO and KEGG analysis were performed using the online website (https://www.omicshare.com/tools/, accessed on 6 April 2022).
4.7. Protein Interaction Network Analysis
Orthologous genes are derived from a common ancestor, and when those between species exhibit a high degree of sequence similarity, they tend to have similar biological functions [51]. As a model plant, A. thaliana protein interactions are accurate and comprehensive. Therefore, the orthovenn2 website (https://orthovenn2.bioinfotoolkits.net/home, accessed on 6 April 2022) [52] was used to search for the orthologous genes of A. thaliana and S. miltiorrhiza. Further, a sequence comparison was conducted to verify the sequence similarity so as to screen genes that may have similar functions to SmBBXs in the AtBBXs. We used the website String10 (http://string-db.org/, accessed on 6 April 2022) to analyze the protein interaction network of AtBBXs and map the protein network of SmBBXs. The minimum required interaction score was set as high confidence (0.7). Finally, Cytoscape 3.7 software was used to map the protein interaction network.
4.8. Subcellular Localization of BBX Proteins
Transcription factors often play key roles in cell nuclei; thus, BBX proteins were located in the nucleus as predicted. To confirm their localization, we developed a pEarleyGate103-SmBBX1/4/9/20/27 vector connected with full-length BBX open reading frames (ORFs) and gene sequences without termination codons using the gateway method. Through biolistic PDS-1000/He, we transformed the plasmid DNA into 3 × 3 cm young onion endocuticle cells, after which the transient expression of SmBBX-GFP was observed using a fluorescence microscope (Leica DM6000B, Wetzlar, Germany) and the nucleus was visualized using DAPI.
4.9. Transactivation Activity Assay of SmBBXs Genes
The ORFs (open reading frames) of SmBBX1, SmBBX4, SmBBX20, SmBBX24, and SmBBX27 were cloned into the pGBKT7 vector using the gateway method to generate the pGBKT7-SmBBX recombinant vector, which was then transformed with the empty vector into the yeast strain AH109, respectively. The transformants carrying the pGBKT7-SmBBXs and empty pGBKT7 (negative control) were cultured on a SD/-Trp solid medium, and once the yeast successfully transformed to the pGBKT7-SmBBXs plasmid, they were expanded with SD/-Trp liquid and diluted to 1, 1/10, 1/100, and 1/1000, which were inoculated (5 μL each) on a SD/-Trp-His-Ade solid medium that contained 5 mg/mL X-α-gal. Proteins with transcriptional activities grew normally on the SD/-Trp-His-Ade solid medium containing 5 mg/mL X-α-gal and turned blue. If the yeast colony did not grow, this meant that the target protein had no transcriptional activation capacity.
4.10. Expression Analysis of SmBBXs Genes Based on Transcriptome Sequencing
Transcriptome sequencing was performed on four different tissues (root, stem, leaf, and flower) of S. miltiorrhiza, and the expression patterns of SmBBXs were further detected. GA-, ABA-, NaCl-, and PEG-treated S. miltiorrhiza were collected at time points for transcriptome sequencing to further detect the change in the SmBBXs expression level. The method for calculating the SmBBXs transcription abundance is estimated in terms of the fragments per kilobase per million mapped fragments (FPKM) [53].
According to the FPKM values of the SmBBXs genes in the transcriptome sequencing results, the expressions of SmBBXs genes under the root, stem, leaf, flower, and abiotic stress were analyzed, and TBtools v1.089 software (Chengjie Chen et al., China) [49] was employed to draw a heat map.
5. Conclusions
In this study, 27 SmBBXs genes were identified and analyzed at the genome-wide level for S. miltiorrhiza, which found that SmBBXs and AtBBXs contained 16 orthologous genes, with which the protein interaction network was constructed to analyze the potential SmBBXs functions. Transcriptome data were employed to analyze the expression patterns of SmBBXs under abiotic stress and different S. miltiorrhiza hormone treatments. Additionally, a transactivation activity assay and the subcellular localization of SmBBXs were analyzed. The results of this study lay a foundation for further research on the functions of SmBBXs under different abiotic stresses, which is of a great significance for the production and breeding of medicinal plants.
Supplementary Materials
The supporting information can be downloaded at: https://www.mdpi.com/10.3390/ijms24032146/s1.
Author Contributions
Z.W., D.W. and Y.L. conceived and designed the experiments; Y.L., J.Y., C.Z., S.H., X.X., Q.T., Y.W., L.L., J.N. and X.C. constructed the vectors and analyzed the data; B.L. and Y.T. sequenced the vectors; Y.L. wrote the manuscript. All authors have read and agreed to the published version of the manuscript.
Funding
This research was supported by the National Natural Science Foundation of China (31870276, 31900254, and 32170378), the Fundamental Research Funds for the Central Universities (GK202205002, GK202205003, GK202205004), the Project of Shaanxi Science and Technology Department (2020JM-628): Shaanxi Administration of Traditional Chinese Medicine Projects (Grant number 2021-QYZL-02, 2021-QYPT-002).
Institutional Review Board Statement
Not applicable.
Informed Consent Statement
Not applicable.
Data Availability Statement
The data presented in this study are available in article and supplementary material.
Conflicts of Interest
The authors declare no conflict of interest.
References
- Khanna, R.; Kronmiller, B.; Maszle, D.R.; Coupland, G.; Holm, M.; Mizuno, T.; Wu, S.H. The Arabidopsis B-box zinc finger family. Plant Cell 2009, 21, 3416–3420. [Google Scholar] [CrossRef]
- Lyu, G.; Li, D.; Li, S. Bioinformatics analysis of BBX family genes and its response to UV-B in Arabidopsis thaliana. Plant Signal. Behav. 2020, 15, 1782647. [Google Scholar] [CrossRef] [PubMed]
- Huang, J.; Zhao, X.; Weng, X.; Wang, L.; Xie, W. The rice B-box zinc finger gene family: Genomic identification, characterization, expression profiling and diurnal analysis. PLoS ONE 2012, 7, e48242. [Google Scholar] [CrossRef] [PubMed]
- Ma, R.; Chen, J.; Huang, B.; Huang, Z.; Zhang, Z. The BBX gene family in Moso bamboo (Phyllostachys edulis): Identification, characterization and expression profiles. BMC Genom. 2021, 22, 533. [Google Scholar] [CrossRef] [PubMed]
- Zhao, J.; Li, H.; Huang, J.; Shi, T.; Meng, Z.; Chen, Q.; Deng, J. Genome-wide analysis of BBX gene family in Tartary buckwheat (Fagopyrum tataricum). PeerJ 2021, 9, e11939. [Google Scholar] [CrossRef]
- Zheng, L.W.; Ma, S.J.; Zhou, T.; Yue, C.P.; Hua, Y.P.; Huang, J.Y. Genome-wide identification of Brassicaceae B-BOX genes and molecular characterization of their transcriptional responses to various nutrient stresses in allotetraploid rapeseed. BMC Plant Biol. 2021, 21, 288. [Google Scholar] [CrossRef]
- Bu, X.; Wang, X.; Yan, J.; Zhang, Y.; Zhou, S.; Sun, X.; Yang, Y.; Ahammed, G.J.; Liu, Y.; Qi, M.; et al. Genome-Wide Characterization of B-Box Gene Family and Its Roles in Responses to Light Quality and Cold Stress in Tomato. Front. Plant Sci. 2021, 12, 698525. [Google Scholar] [CrossRef]
- Gangappa, S.N.; Botto, J.F. The BBX family of plant transcription factors. Trends Plant Sci. 2014, 19, 460–470. [Google Scholar] [CrossRef]
- Cao, J.; Yuan, J.; Zhang, Y.; Chen, C.; Zhang, B.; Shi, X.; Niu, R. Multi-layered roles of BBX proteins in plant growth and development. Stress Biol. 2023, 3, 1. [Google Scholar] [CrossRef]
- Zhang, B.; Yang, H.J.; Qu, D.; Zhu, Z.Z.; Yang, Y.Z.; Zhao, Z.Y. The MdBBX22-miR858-MdMYB9/11/12 module regulates proanthocyanidin biosynthesis in apple peel. Plant Biotechnol. J. 2022, 20, 1683–1700. [Google Scholar] [CrossRef]
- An, J.P.; Wang, X.F.; Espley, R.V.; Lin-Wang, K.; Bi, S.Q.; You, C.X.; Hao, Y.J. An Apple B-Box Protein MdBBX37 Modulates Anthocyanin Biosynthesis and Hypocotyl Elongation Synergistically with MdMYBs and MdHY5. Plant Cell Physiol. 2020, 61, 130–143. [Google Scholar] [CrossRef] [PubMed]
- An, J.P.; Zhang, C.L.; Li, H.L.; Wang, G.L.; You, C.X. Apple SINA E3 ligase MdSINA3 negatively mediates JA-triggered leaf senescence by ubiquitinating and degrading the MdBBX37 protein. Plant J. Cell Mol. Biol. 2022, 111, 457–472. [Google Scholar] [CrossRef] [PubMed]
- Luo, D.; Xiong, C.; Lin, A.; Zhang, C.; Sun, W.; Zhang, J.; Yang, C.; Lu, Y.; Li, H.; Ye, Z.; et al. SlBBX20 interacts with the COP9 signalosome subunit SlCSN5-2 to regulate anthocyanin biosynthesis by activating SlDFR expression in tomato. Hortic. Res. 2021, 8, 163. [Google Scholar] [CrossRef] [PubMed]
- Yang, G.; Zhang, C.; Dong, H.; Liu, X.; Guo, H.; Tong, B.; Fang, F.; Zhao, Y.; Yu, Y.; Liu, Y.; et al. Activation and negative feedback regulation of SlHY5 transcription by the SlBBX20/21-SlHY5 transcription factor module in UV-B signaling. Plant Cell 2022, 34, 2038–2055. [Google Scholar] [CrossRef]
- Lin, F.; Jiang, Y.; Li, J.; Yan, T.; Fan, L.; Liang, J.; Chen, Z.J.; Xu, D.; Deng, X.W. B-BOX DOMAIN PROTEIN28 Negatively Regulates Photomorphogenesis by Repressing the Activity of Transcription Factor HY5 and Undergoes COP1-Mediated Degradation. Plant Cell 2018, 30, 2006–2019. [Google Scholar] [CrossRef]
- Cao, J.; Liang, Y.; Yan, T.; Wang, X.; Zhou, H.; Chen, C.; Zhang, Y.; Zhang, B.; Zhang, S.; Liao, J.; et al. The photomorphogenic repressors BBX28 and BBX29 integrate light and brassinosteroid signaling to inhibit seedling development in Arabidopsis. Plant Cell 2022, 34, 2266–2285. [Google Scholar] [CrossRef]
- Veciana, N.; Martín, G.; Leivar, P.; Monte, E. BBX16 mediates the repression of seedling photomorphogenesis downstream of the GUN1/GLK1 module during retrograde signalling. New Phytol. 2022, 234, 93–106. [Google Scholar] [CrossRef]
- Yuan, L.; Yu, Y.; Liu, M.; Song, Y.; Li, H.; Sun, J.; Wang, Q.; Xie, Q.; Wang, L.; Xu, X. BBX19 fine-tunes the circadian rhythm by interacting with PSEUDO-RESPONSE REGULATOR proteins to facilitate their repressive effect on morning-phased clock genes. Plant Cell 2021, 33, 2602–2617. [Google Scholar] [CrossRef]
- Li, Y.; Shi, Y.; Li, M.; Fu, D.; Wu, S.; Li, J.; Gong, Z.; Liu, H.; Yang, S. The CRY2-COP1-HY5-BBX7/8 module regulates blue light-dependent cold acclimation in Arabidopsis. Plant Cell 2021, 33, 3555–3573. [Google Scholar] [CrossRef]
- Liu, Y.; Chen, H.; Ping, Q.; Zhang, Z.; Guan, Z.; Fang, W.; Chen, S.; Chen, F.; Jiang, J.; Zhang, F. The heterologous expression of CmBBX22 delays leaf senescence and improves drought tolerance in Arabidopsis. Plant Cell Rep. 2019, 38, 15–24. [Google Scholar] [CrossRef]
- Xia, P.; Hu, W.; Liang, T.; Yang, D.; Liang, Z. An attempt to establish an Agrobacterium-mediated transient expression system in medicinal plants. Protoplasma 2020, 257, 1497–1505. [Google Scholar] [CrossRef] [PubMed]
- Xu, H.; Song, J.; Luo, H.; Zhang, Y.; Li, Q.; Zhu, Y.; Xu, J.; Li, Y.; Song, C.; Wang, B.; et al. Analysis of the Genome Sequence of the Medicinal Plant Salvia miltiorrhiza. Mol. Plant 2016, 9, 949–952. [Google Scholar] [CrossRef] [PubMed]
- Xu, Z.-c.; Ji, A.-j.; Zhang, X.; Song, J.-y.; Chen, S.-l. Biosynthesis and Regulation of Active Compounds in Medicinal Model Plant Salvia miltiorrhiza. Chin. Herb. Med. 2016, 8, 3–11. [Google Scholar] [CrossRef]
- Kiełbowicz-Matuk, A.; Rey, P.; Rorat, T. Interplay between circadian rhythm, time of the day and osmotic stress constraints in the regulation of the expression of a Solanum Double B-box gene. Ann. Bot. 2014, 113, 831–842. [Google Scholar] [CrossRef]
- Wang, C.Q.; Guthrie, C.; Sarmast, M.K.; Dehesh, K. BBX19 interacts with CONSTANS to repress FLOWERING LOCUS T transcription, defining a flowering time checkpoint in Arabidopsis. Plant Cell 2014, 26, 3589–3602. [Google Scholar] [CrossRef] [PubMed]
- Imtiaz, M.; Yang, Y.; Liu, R.; Xu, Y.; Khan, M.A.; Wei, Q.; Gao, J.; Hong, B. Identification and functional characterization of the BBX24 promoter and gene from chrysanthemum in Arabidopsis. Plant Mol. Biol. 2015, 89, 1–19. [Google Scholar] [CrossRef] [PubMed]
- Zhang, X.; Huai, J.; Shang, F.; Xu, G.; Tang, W.; Jing, Y.; Lin, R. A PIF1/PIF3-HY5-BBX23 Transcription Factor Cascade Affects Photomorphogenesis. Plant Physiol. 2017, 174, 2487–2500. [Google Scholar] [CrossRef]
- Wang, Q.; Zeng, J.; Deng, K.; Tu, X.; Zhao, X.; Tang, D.; Liu, X. DBB1a, involved in gibberellin homeostasis, functions as a negative regulator of blue light-mediated hypocotyl elongation in Arabidopsis. Planta 2011, 233, 13–23. [Google Scholar] [CrossRef]
- Xu, Y.; Zhao, X.; Aiwaili, P.; Mu, X.; Zhao, M.; Zhao, J.; Cheng, L.; Ma, C.; Gao, J.; Hong, B. A zinc finger protein BBX19 interacts with ABF3 to affect drought tolerance negatively in chrysanthemum. Plant J. Cell Mol. Biol. 2020, 103, 1783–1795. [Google Scholar] [CrossRef]
- Min, J.H.; Chung, J.S.; Lee, K.H.; Kim, C.S. The CONSTANS-like 4 transcription factor, AtCOL4, positively regulates abiotic stress tolerance through an abscisic acid-dependent manner in Arabidopsis. J. Integr. Plant Biol. 2015, 57, 313–324. [Google Scholar] [CrossRef]
- Job, N.; Yadukrishnan, P.; Bursch, K.; Datta, S.; Johansson, H. Two B-Box Proteins Regulate Photomorphogenesis by Oppositely Modulating HY5 through their Diverse C-Terminal Domains. Plant Physiol. 2018, 176, 2963–2976. [Google Scholar] [CrossRef] [PubMed]
- Bai, S.; Tao, R.; Yin, L.; Ni, J.; Yang, Q.; Yan, X.; Yang, F.; Guo, X.; Li, H.; Teng, Y. Two B-box proteins, PpBBX18 and PpBBX21, antagonistically regulate anthocyanin biosynthesis via competitive association with Pyrus pyrifolia ELONGATED HYPOCOTYL 5 in the peel of pear fruit. Plant J. Cell Mol. Biol. 2019, 100, 1208–1223. [Google Scholar] [CrossRef]
- Li, C.; Pei, J.; Yan, X.; Cui, X.; Tsuruta, M.; Liu, Y.; Lian, C. A poplar B-box protein PtrBBX23 modulates the accumulation of anthocyanins and proanthocyanidins in response to high light. Plant Cell Environ. 2021, 44, 3015–3033. [Google Scholar] [CrossRef] [PubMed]
- Li, X.; He, Y.; Xie, C.; Zu, Y.; Zhan, F.; Mei, X.; Xia, Y.; Li, Y. Effects of UV-B radiation on the infectivity of Magnaporthe oryzae and rice disease-resistant physiology in Yuanyang terraces. Photochem. Photobiol. Sci. 2018, 17, 8–17. [Google Scholar] [CrossRef]
- Hatier, J.H.; Clearwater, M.J.; Gould, K.S. The functional significance of black-pigmented leaves: Photosynthesis, photoprotection and productivity in Ophiopogon planiscapus ‘Nigrescens’. PLoS ONE 2013, 8, e67850. [Google Scholar] [CrossRef] [PubMed]
- Peng, Y.; Yan, Y.; Wan, P.; Dong, W.; Huang, K.; Ran, L.; Mi, J.; Lu, L.; Zeng, X.; Cao, Y. Effects of long-term intake of anthocyanins from Lycium ruthenicum Murray on the organism health and gut microbiota in vivo. Food Res. Int. 2020, 130, 108952. [Google Scholar] [CrossRef]
- Song, Z.; Yan, T.; Liu, J.; Bian, Y.; Heng, Y.; Lin, F.; Jiang, Y.; Wang Deng, X.; Xu, D. BBX28/BBX29, HY5 and BBX30/31 form a feedback loop to fine-tune photomorphogenic development. Plant J. 2020, 104, 377–390. [Google Scholar] [CrossRef]
- Gangappa, S.N.; Botto, J.F. The Multifaceted Roles of HY5 in Plant Growth and Development. Mol. Plant 2016, 9, 1353–1365. [Google Scholar] [CrossRef]
- Yadav, A.; Ravindran, N.; Singh, D.; Rahul, P.V.; Datta, S. Role of Arabidopsis BBX proteins in light signaling. J. Plant Biochem. Biotechnol. 2020, 29, 623–635. [Google Scholar] [CrossRef]
- Bursch, K.; Toledo-Ortiz, G.; Pireyre, M.; Lohr, M.; Braatz, C.; Johansson, H. Identification of BBX proteins as rate-limiting cofactors of HY5. Nat. Plants 2020, 6, 921–928. [Google Scholar] [CrossRef]
- Poole, R.L. The TAIR database. Methods Mol. Biol. 2007, 406, 179–212. [Google Scholar] [CrossRef] [PubMed]
- Chandran, A.K.N.; Jung, K.H. Resources for systems biology in rice. J. Plant Biol. 2014, 57, 80–92. [Google Scholar] [CrossRef]
- Mistry, J.; Chuguransky, S.; Williams, L.; Qureshi, M.; Salazar, G.A.; Sonnhammer, E.; Tosatto, S.; Paladin, L.; Raj, S.; Richardson, L.J.; et al. Pfam: The protein families database in 2021. Nucleic Acids Res. 2021, 49, D412–D419. [Google Scholar] [CrossRef] [PubMed]
- Schultz, J.; Milpetz, F.; Bork, P.; Ponting, C.P. SMART, a simple modular architecture research tool:identification of signaling domains. Proc. Natl. Acad. Sci. USA 1998, 95, 5857–5864. [Google Scholar] [CrossRef]
- Kumar, S.; Stecher, G.; Li, M.; Knyaz, C.; Tamura, K. MEGA X: Molecular Evolutionary Genetics Analysis across Computing Platforms. Mol. Biol. Evol. 2018, 35, 1547–1549. [Google Scholar] [CrossRef]
- Li, K.B. ClustalW-MPI: ClustalW analysis using distributed and parallel computing. Bioinformatics 2003, 19, 1585–1586. [Google Scholar] [CrossRef]
- Artimo, P.; Jonnalagedda, M.; Arnold, K.; Baratin, D.; Csardi, G.; de Castro, E.; Duvaud, S.; Flegel, V.; Fortier, A.; Gasteiger, E.; et al. ExPASy: SIB bioinformatics resource portal. Nucleic Acids Res. 2012, 40, W597–W603. [Google Scholar] [CrossRef]
- Bailey, T.L.; Boden, M.; Buske, F.A.; Frith, M.; Grant, C.E.; Clementi, L.; Ren, J.; Li, W.W.; Noble, W.S. MEME SUITE: Tools for motif discovery and searching. Nucleic Acids Res. 2009, 37, W202–W208. [Google Scholar] [CrossRef]
- Chen, C.; Chen, H.; Zhang, Y.; Thomas, H.R.; Frank, M.H.; He, Y.; Xia, R. TBtools: An integrative toolkit developed for interactive analyses of big biological data. Mol. Plant 2020, 13, 1194–1202. [Google Scholar] [CrossRef]
- Lescot, M.; Dehais, P.; Thijs, G.; Marchal, K.; Moreau, Y.; Van de Peer, Y.; Rouze, P.; Rombauts, S. PlantCARE, a database of plant cis-acting regulatory elements and a portal to tools for in silico analysis of promoter sequences. Nucleic Acids Res. 2002, 30, 325–327. [Google Scholar] [CrossRef]
- Moreira, D. Orthologous Gene. In Encyclopedia of Astrobiology; Springer: Berlin/Heidelberg, Germany, 2014. [Google Scholar] [CrossRef]
- Xu, L.; Dong, Z.; Fang, L.; Luo, Y.; Wei, Z.; Guo, H.; Zhang, G.; Gu, Y.Q.; Coleman-Derr, D.; Xia, Q.; et al. OrthoVenn2: A web server for whole-genome comparison and annotation of orthologous clusters across multiple species. Nucleic Acids Res. 2019, 47, W52–W58. [Google Scholar] [CrossRef] [PubMed]
- Trapnell, C.; Williams, B.A.; Pertea, G.; Mortazavi, A.; Kwan, G.; Van Baren, M.J.; Salzberg, S.L.; Wold, B.J.; Pachter, L. Transcript assembly and quantification by RNA-Seq reveals unannotated transcripts and isoform switching during cell differentiation. Nat. Biotechnol. 2010, 28, 511–515. [Google Scholar] [CrossRef] [PubMed]
Disclaimer/Publisher’s Note: The statements, opinions and data contained in all publications are solely those of the individual author(s) and contributor(s) and not of MDPI and/or the editor(s). MDPI and/or the editor(s) disclaim responsibility for any injury to people or property resulting from any ideas, methods, instructions or products referred to in the content. |
© 2023 by the authors. Licensee MDPI, Basel, Switzerland. This article is an open access article distributed under the terms and conditions of the Creative Commons Attribution (CC BY) license (https://creativecommons.org/licenses/by/4.0/).


























